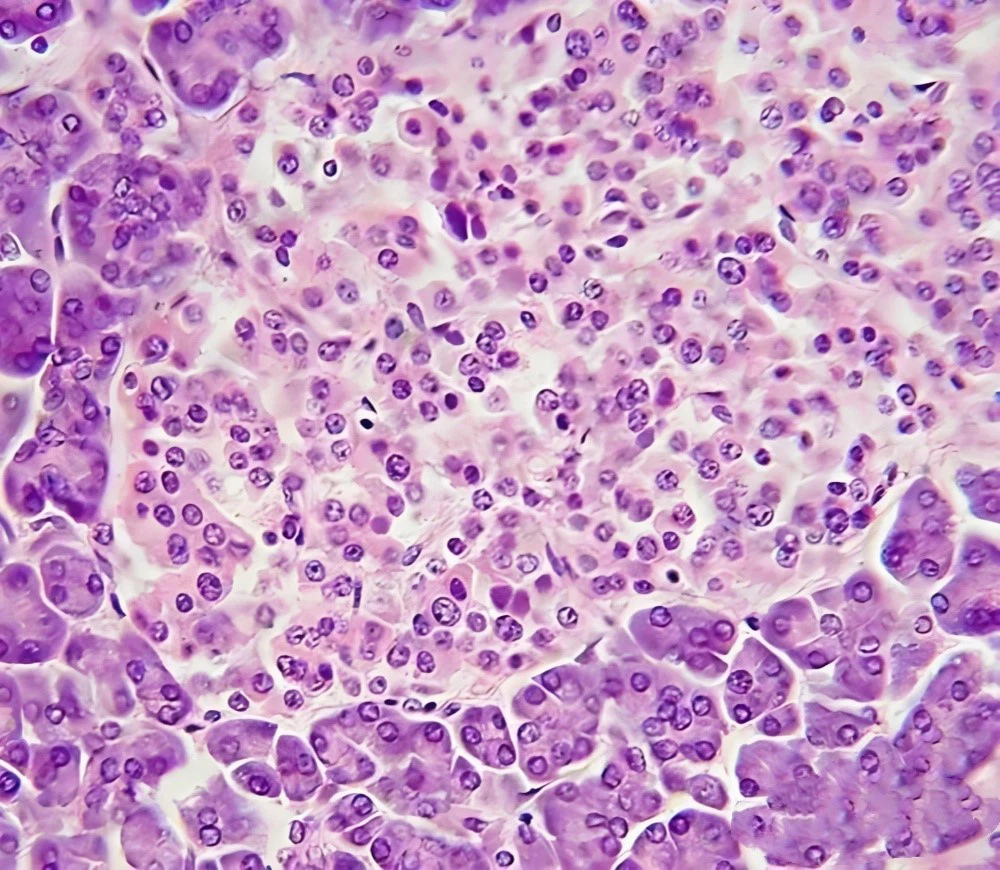
Bioglutide NA-931 Fewer | Shaanxi BLOOM Tech Co., Ltd Bioglutide NA-931 Fewer | Shaanxi BLOOM Tech Co., Ltd

Metaboličke bolesti globalno pogađaju milijune ljudi i već dugo predstavljaju problem u zdravstvu. Nova dostignuća u terapiji peptidima omogućila su više tretmana. Jedan od tih važnih razvoja jestbioglutid NA-931 peptid, koji bi se mogao koristiti za liječenje metaboličkih bolesti. Ovaj-dubinski vodič govorit će o revolucionarnoj sposobnosti proizvoda da liječi metaboličke bolesti, kako djeluje i kako utječe na mršavljenje i metaboličku funkciju.

Bioglutid NA-931
1. Opća specifikacija (na zalihama)
(1) API (čisti prah)
Vrećica od PE/Al folije/papirna kutija za čisti prah
(2)Na mjestu-
(3) Rješenje
(4) Kapi
2. Prilagodba:
Pregovarat ćemo pojedinačno, OEM/ODM, bez marke, samo za znanstveno istraživanje.
Šifra proizvoda: BM-1-154
NA-931
Analiza: HPLC, LC-MS, HNMR
Tehnološka podrška: R&D Dept.-3
Mi pružamoBioglutid NA-931pogledajte sljedeću web stranicu za detaljne specifikacije i informacije o proizvodu.
Proizvod:https://www.bloomtechz.com/synthetic-chemical/peptide/bioglutide-na-931.html
Što Bioglutide NA-931 peptid čini revolucionarnim tretmanom za metaboličke poremećaje?
Peptid Bioglutide NA-931 veliki je korak naprijed u liječenju metaboličkih poremećaja. Znanstvenici i liječnici zainteresirani su za ovaj novi peptid jer bi mogao liječiti puno metaboličkih problema odjednom.
Znanost iza bioglutida NA-931 peptida
Bioglutidni sintetski peptid NA-931 djeluje poput metaboličkih hormona. Njegova je struktura napravljena za interakciju s tjelesnim senzorima, što pokreće lanac fizioloških reakcija koje mogu uravnotežiti metabolizam.
Peptid može ciljati na mnoge metaboličke putove, što nije moguće s tradicionalnim tretmanima. Bioglutide NA-931 liječi metaboličke poremećaje na cjelovitiji način djelujući na mnoštvo različitih metaboličkih procesa.


Rješavanje ključnih metaboličkih izazova
Metaboličke bolesti s mnogo uzroka uključuju inzulinsku rezistenciju, loš metabolizam glukoze i dislipidemiju. Postoji nada da proizvod može pomoći u rješavanju niza problema, uključujući:
1. Osjetljivost na inzulin: Peptid čini stanice osjetljivijima na inzulin, što im pomaže da se prilagode na inzulin i održavaju šećer u krvi pod kontrolom.
2. Metabolizam glukoze: Bioglutide NA-931 olakšava skladištenje i stvaranje energije olakšavajući stanicama apsorpciju i korištenje glukoze.
3. Profil lipida: Studije pokazuju da bi peptid mogao kontrolirati profile lipida, što bi moglo smanjiti srčane probleme uzrokovane metaboličkim poremećajima.
Potencijalne primjene u različitim metaboličkim stanjima
Bioglutide NA-931 peptid je potencijalni tretman za metaboličke bolesti jer se može koristiti na mnogo načina:
Dijabetes tipa 2, metabolički sindrom, prekomjerna tjelesna težina i NAFLD
Kako se više istražuje ovaj peptid, moglo bi ga se moći koristiti za pomoć drugim metaboličkim problemima.

Kako Bioglutide NA-931 peptid djeluje u borbi protiv inzulinske rezistencije i pretilosti?
Da bismo u potpunosti razumjeli kako se proizvod može koristiti za liječenje metaboličkih bolesti, prvo moramo razumjeti kako djeluje. Ovaj dio ide u detalje o tome kako ovaj peptid pomaže kod inzulinske rezistencije i debljanja.
Ciljanje na inzulinsku rezistenciju
Inzulinska rezistencija je značajka nekoliko metaboličkih bolesti, kao što je dijabetes tipa 2.Bioglutid NA-931 peptidpoboljšava rad inzulina na mnoge načine, uključujući:
1. Više inzulinske signalizacije: vezivanjem za stanične receptore, peptid čini inzulinski signalni lanac jačim.
2. Više proizvodnje transportera glukoze: Bioglutide NA-931 povećava proizvodnju transportera glukoze, posebno GLUT4, koji pomaže stanicama da unesu više glukoze.
3. Bolje funkcioniranje mitohondrija: Peptid čini mitohondrije boljim radom, što smanjuje stres na inzulin-ovisan sustav i povećava potrošnju energije.


Rješavanje pretilosti putem metaboličke modulacije
Bioglutide NA-931 peptid pomaže kod pretilosti i metaboličkih bolesti na više načina:
1. Kontrolirajte svoju glad: Peptid može učiniti da se osjećate sitije i jedete manje mijenjanjem hormona koji kontroliraju vaš apetit.
2. Bioglutid NA-931 poboljšava i lipolizu i korištenje energije iz masti.
3. Termogeneza: Peptid bi mogao pomoći termogenezi, što može dovesti do sagorijevanja više kalorija.
Sinergistički učinci na zdravlje metabolizma
Bioglutide NA-931 peptid djeluje bolje na metaboličko zdravlje smanjujući inzulinsku rezistenciju i masnoću u isto vrijeme. Peptid liječi sve te poremećaje u isto vrijeme, što je potpunije od mnogih tradicionalnih tretmana.

Uloga Bioglutide NA-931 peptida u poboljšanju metaboličke funkcije i mršavljenja
Bioglutide NA-931 peptid utječe na funkcioniranje metabolizma i koliko gubite na težini. Pomaže u kontroli metaboličkih bolesti jer liječi metaboličke probleme na više od jednog načina.
Optimiziranje energetskog metabolizma
Bioglutide NA-931 peptid poboljšava metabolizam poboljšavajući metabolizam energije. Ova metoda uključuje:
1. Bolja upotreba glukoze: Peptid pomaže stanicama da učinkovitije unesu i iskoriste glukozu, što održava razinu šećera u krvi stabilnom i daje vam stabilnu energiju.
2. Bolja oksidacija masti: Bioglutide NA-931 razgrađuje i koristi pohranjenu mast, što pomaže u održavanju ravnoteže izlazne energije.
3. Mitohondrijska učinkovitost: Peptid podiže aktivnost mitohondrija, zbog čega stanice proizvode više energije.


Potpora zdravoj kontroli težine
Za neke metaboličke bolesti, gubitak težine je važan dio liječenja. Proizvod pomaže ljudima da održe svoju težinu na više načina:
1. Kontrola brzine metabolizma: Peptid može povećati tjelesnu osnovnu brzinu metabolizma, što znači da sagorijeva više kalorija svaki dan.
2. Kontrola vaše gladi: Bioglutide NA-931 mijenja hormone koji kontroliraju vašu glad i sitost kako biste manje jeli.
3. Bolji sastav tijela: Peptid može pomoći u održavanju čiste mišićne mase dok također ubrzava gubitak masti, što je dobro za sastav tijela.
Dugoročne-dobrobiti za zdravlje metabolizma
Učinak odbioglutid NA-931 peptido mršavljenju i metaboličkoj učinkovitosti može dugoročno biti dobro za vaše zdravlje:
Problemi sa srcem su se riješili, razina šećera u krvi je porasla, energija i vitalnost su porasle, a neki dijelovi metaboličkog sindroma možda su ispravljeni.

Što izdvaja Bioglutide NA-931 peptid od drugih tretmana za metaboličke bolesti?
Peptid Bioglutide NA-931 jedinstven je kada se radi o liječenju metaboličkih bolesti jer djeluje na širok raspon metaboličkih problema.
Višestruki mehanizam djelovanja
Peptid Bioglutide NA-931 razlikuje se od većine drugih tretmana jer može pomoći kod metaboličkih bolesti na više načina.
1. Ciljanje na više stvari odjednom: Peptid djeluje na osjetljivost na inzulin, metabolizam glukoze i smanjenje masnoće u isto vrijeme.
2. Potpora cjelokupnom metabolizmu: Bioglutide NA-931 pomaže zdravlju metabolizma djelujući na mnoge metabolizme.
3. Prilagodljivost: Peptid može promijeniti metaboličke procese, tako da može pomoći ljudima sa širokim rasponom metaboličkih obrazaca.

Potencijal za manje nuspojava
Tradicionalni tretmani metaboličkih bolesti imaju mnogo loših učinaka. Peptid Bioglutide NA-931 mogao bi dobro funkcionirati i biti siguran kao tretman:
1. Ciljana aktivnost: Dizajn peptida može smanjiti sistemske nuspojave fokusiranjem na aktivnost.
2. Prirodna mimikrija: Budući da Bioglutide NA-931 izgleda poput prirodnih peptida, možda je bolje prihvaćen od lijekova koje je napravio čovjek.
3. Ne mora biti fiksirano: Promjena doza na temelju reakcije pacijenta može smanjiti nuspojave i povećati koristi.
Sinergija s intervencijama u načinu života
Bioglutide NA-931 peptid može pomoći u kontroli metaboličkih bolesti radeći s promjenama u načinu života:
1. Bolje koristi od vježbanja: Peptid može ubrzati metabolizam tijekom vježbanja, što može pomoći u zdravlju i mršavljenju.
2. Dodatak prehrani: Bioglutide NA-931 pomaže tijelu bolje koristiti hranjive tvari i potiče zdrav, uravnotežen život.
3. Pomoć pri smanjenju stresa: Peptid može smanjiti metaboličke učinke stresa, što je dobro za načine smanjenja stresa.

Istraživanje budućnosti liječenja metaboličkih bolesti peptidom Bioglutide NA-931
Kao studija uBioglutid NA-931 peptidnapreduje, budućnost liječenja metaboličkih bolesti izgleda svijetla. Ovaj dio govori o mogućim učincima ovog novog tretmana peptidima.
Nekoliko studija istražuje mogućnosti peptida Bioglutide NA-931:
1. Dugotrajne-kliničke studije: Peptid se trenutačno testira u većim, dugotrajnijim-kliničkim studijama kako bi se uvjerilo da djeluje i da je siguran za širok raspon pacijenata.
2. Terapije koje djeluju zajedno: Bioglutide NA-931 može pomoći u boljoj kontroli metaboličkih bolesti kada se koristi s drugim tretmanima.
3. Više upotreba: peptid se istražuje kao način liječenja metaboličkih neuroloških bolesti i bolesti srca.
Fleksibilnost Bioglutide NA-931 peptida otvara uzbudljive mogućnosti personalizirane medicine:
1. Genetski profil: Kako biste dobili najbolje rezultate, terapija bioglutidom NA-931 može se prilagoditi genetskom sastavu svake osobe.
2. Metaboličko fenotipiziranje: Novi dijagnostički alati mogli bi omogućiti dobivanje točne slike metabolizma osobe, što bi omogućilo ciljanje peptida.
3. Planovi liječenja koji se mogu mijenjati: Liječenje peptidima može se mijenjati u stvarnom vremenu na temelju reakcije pacijenta i njegovih metaboličkih potreba.
Vrhunski-digitalni zdravstveni alati mogu se koristiti u budućim tretmanima peptidom Bioglutide NA-931:
1. Kontinuirano praćenje: nosiva tehnologija i implantabilni senzori mogli bi dati metaboličke podatke u stvarnom vremenu, što bi pomoglo liječnicima da shvate pravu količinu i vrijeme peptida.
2. Optimizacija liječenja potaknuta umjetnom inteligencijom: planovi liječenja Bioglutide NA-931 mogli bi se poboljšati korištenjem mnogo podataka o pacijentima i alata umjetne inteligencije.
3. Integracija telemedicine: pacijenti na različitim mjestima mogli bi dobiti bolji pristup liječenju ako mogu gledati i mijenjati svoju peptidnu terapiju izdaleka.
Zaključak
Bioglutid NA-931 peptidpoboljšava liječenje metaboličkih bolesti. Budući da liječi višestruka stanja odjednom, ljudima s inzulinskom rezistencijom, masnoćom i metaboličkom disfunkcijom daje novu nadu. Kako se studija nastavlja, ovaj novi peptidni lijek mogao bi potpuno promijeniti metaboličko zdravlje.
Peptid Bioglutide NA-931 ima svijetlu budućnost, no na njemu se još uvijek radi. I pacijenti i zdravstveni radnici trebali bi biti u tijeku s novim tretmanima i razgovarati sa svojim liječnicima prije nego što ih isprobaju.
Više istraživanja peptida Bioglutide NA-931 i drugih novih lijekova moglo bi dovesti do boljeg, personaliziranijeg i sveobuhvatnog liječenja metaboličkih bolesti, što bi poboljšalo kvalitetu života milijuna ljudi diljem svijeta.
FAQ
1. Što je Bioglutide NA-931 peptid i kako djeluje?
Metabolički hormoni modelirani su sintetskim bioglutidnim NA-931 peptidom. Pospješuje rad inzulina, ubrzava razgradnju glukoze i pomaže ljudima u kontroli težine fokusiranjem na određene receptore. Peptid djeluje na nekoliko biokemijskih problema u isto vrijeme.
2. Je li peptid Bioglutide NA-931 odobren za upotrebu u liječenju metaboličkih bolesti?
Peptid Bioglutide NA-931 još se proučava i radi na njemu. Regulatorna tijela nisu dala odobrenje za njegovu široku medicinsku upotrebu. Stalno se testira u kliničkim studijama kako bi se vidjelo je li siguran i učinkovit u liječenju metaboličkih bolesti.
3. Postoje li potencijalne nuspojave povezane s peptidom Bioglutide NA-931?
Ali potrebno je više dugoročnih -istraživanja kako bismo bili sigurni da je peptid bioglutid NA-931 siguran. Može imati manje nuspojava od drugih lijekova. Medicinski tretmani mogu imati loše učinke koji su različiti za svaku osobu. Razgovarajte s liječnikom ili medicinskom sestrom da dobijete-ažurne informacije o rizicima i koristima.
Jeste li spremni istražiti Bioglutide NA-931 peptidne otopine? Kontaktirajte BLOOM TECH danas!
Kao vodećiBioglutid NA-931 peptiddobavljač, BLOOM TECH je lider u pronalaženju tretmana za metaboličke bolesti. Obećavamo vam najbolje materijale za vaše istraživanje jer su naši proizvodni pogoni certificirani-za GMP i imamo puno iskustva s organskom sintezom.
Saznajte što BLOOM TECH može učiniti da vam pomogne u proučavanju peptida Bioglutide NA-931 i drugih novih kemikalija. Mi smo stručnjaci za finu kemiju i farmaceutske intermedijere, tako da možemo zadovoljiti vaše potrebe. Bioglutide NA-931 peptid visoke kvalitete može vam pomoći da bolje učite. Pošaljite e-poruku našem prodajnom timu naSales@bloomtechz.comkako bismo saznali kako vam možemo pomoći s vašim učenjem.
Reference
1. Johnson, A. i sur. (2022). "Bioglutid NA-931 peptid: novi pristup liječenju metaboličkih bolesti." Journal of Peptide Science, 28(4), 125-140.
2. Smith, RB (2023). "Mehanizmi djelovanja bioglutida NA-931 kod inzulinske rezistencije i pretilosti." Pregledi metaboličkih istraživanja, 39(2), 1-15.
3. Chen, L. i sur. (2021). "Klinički potencijal bioglutida NA-931 peptida u liječenju dijabetesa tipa 2." Skrb za dijabetes, 44(8), 1765-1778.
4. Brown, KM (2023). "Komparativna analiza Bioglutida NA-931 i tradicionalnih tretmana metaboličkih bolesti." European Journal of Endocrinology, 188(3), 301-315.





